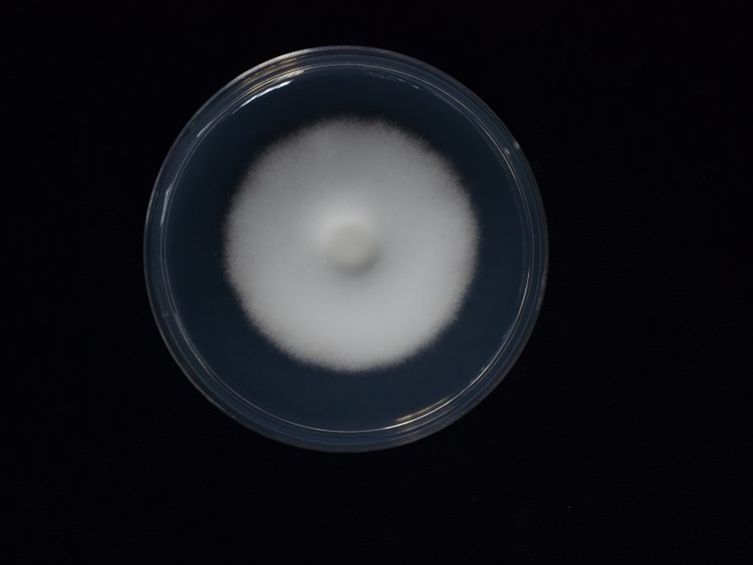

Holotype:
THAILAND, Narathiwat Province, Hala Bala Wildlife Sanctuary, 3 Mar. 2009, K. Tasanathai, P. Puyngain, T. Chohmee, holotype BBH 26019, ex-type living culture BCC 36265.
Habitat:
Underside of leaf.
Host:
Adult moths (Noctuidae; Lepidoptera).
Description:
Adult moth attached to the midrib of monocotyledonous leaf or undersides of dicotyledonous leaf covered by white to cream mycelium.  Stroma arising from host body and wing veins, white to cream, cylindrical, length ca 5 mm.
Stroma arising from host body and wing veins, white to cream, cylindrical, length ca 5 mm.  Perithecia superficial, orange to light brown, few to numerous, crowded at the tip of the stroma or growing directly from mycelium in host body and wing veins, ovoid, 530-1000 × 290-425 μm.
Perithecia superficial, orange to light brown, few to numerous, crowded at the tip of the stroma or growing directly from mycelium in host body and wing veins, ovoid, 530-1000 × 290-425 μm.  Asci cylindrical, hyaline, 170-550 × 2-4 μm.
Asci cylindrical, hyaline, 170-550 × 2-4 μm.  Ascospores cylindrical, filiform, hyaline, multi-septate, breaking into one-celled fragments at maturity, 6-13 × 1 μm. Anamorph: Synnemata arising from moth body and wing veins, white to cream, erect, simple, cylindrical to clavate, 650-1500 × 50-120 μm. Conidiogenous cells produced along the synnemata, monophialidic or polyphialidic.
Ascospores cylindrical, filiform, hyaline, multi-septate, breaking into one-celled fragments at maturity, 6-13 × 1 μm. Anamorph: Synnemata arising from moth body and wing veins, white to cream, erect, simple, cylindrical to clavate, 650-1500 × 50-120 μm. Conidiogenous cells produced along the synnemata, monophialidic or polyphialidic.  Phialides cylindrical with papillate end, hyaline, 5-10 × 1.8-3 μm.
Phialides cylindrical with papillate end, hyaline, 5-10 × 1.8-3 μm.  Conidia cylindrical with round end, hyaline, 3-6 × 1 μm.
Conidia cylindrical with round end, hyaline, 3-6 × 1 μm.
Culture characteristics:
Colony on PDA growing with a diam of 20–24 mm in 14 d, circular, flat to raised, entire edges, white and fluffy mycelium. Colony reverse cream. Conidia and reproductive structures not observed.
Colony on PDA growing with a diam of 20–24 mm in 14 d, circular, flat to raised, entire edges, white and fluffy mycelium. Colony reverse cream. Conidia and reproductive structures not observed.
Reference:
Aini AN, Mongkolsamrit S, Wijanarka W, et al. (2020). Diversity of Akanthomyces on moths (Lepidoptera) in Thailand. MycoKeys 71: 1–22.
DOI: http://doi.org/10.3897/mycokeys.71.55126Species |
Strain |
Compound |
Pubchem CID |
Biological activity |
Reference |
|---|
|
Strain |
ITS | LSU | RPB1 | RPB2 | TEF1 |
|---|---|---|---|---|---|
| BBH 16595 | MT356073 | MT356085 | MT477995 | MT478005 | MT477979 |
| BCC 28571 | MT356075 | MT356087 | MT478009 | MT478006 | MT477981 |
| BCC 36265 | MT356072 | MT356084 | MT477994 | MT477987 | MT477978 |
| BCC 47498 | MT356074 | MT356086 | MT477996 | MT477988 | MT477980 |